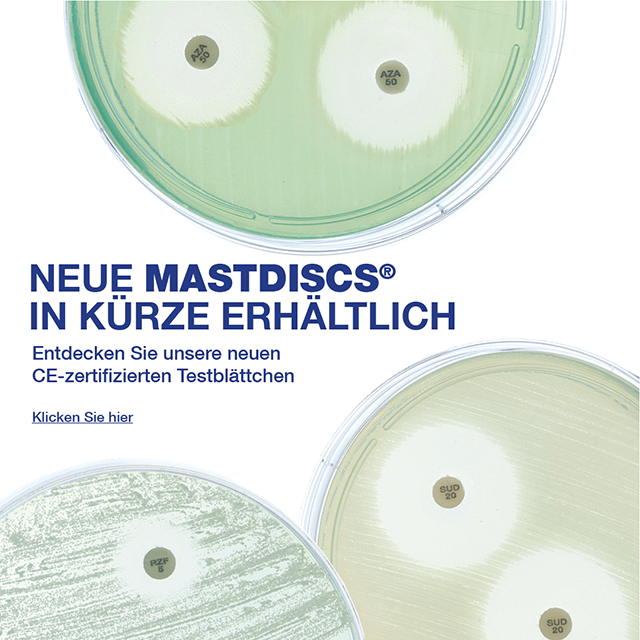
Neue MASTDISCS

Neue MASTDISCS® in Kürze erhältlich

Wir freuen uns, Ihnen mitteilen zu können, dass drei neue MASTDISCS®-Produkte zur Bestimmung der antimikrobiellen Empfindlichkeit in Kürze mit CE-Kennzeichnung erhältlich sind: AZA50C, RZF5C und SUD20C.
Die CE-Kennzeichnung erweitert den internationalen Zugang zu diesen wichtigen AST-Produkten und unterstützt klinische Labore weltweit bei der Durchführung zuverlässiger antimikrobieller Empfindlichkeitstestungen von klinisch relevanten bakteriellen und mykotischen Krankheitserreger, einschließlich solcher, die mit schweren und arzneimittelresistenten Infektionen in Verbindung stehen.
Zu den Neuzugängen in unserem CE-gekennzeichneten Sortiment gehören:
- AZA50C (Aztreonam 30 µg/Avibactam 20 µg) für Empfindlichkeitstests von multiresistenten gramnegativen Organismen
- RZF5C (Rezafungin 5 µg) für Empfindlichkeitstests in Bezug auf Candida Spezies
- SUD20C (Sulbactam 10 µg/Durlobactam 10 µg) für Empfindlichkeitstests gegen den Acinetobacter baumannii-calcoaceticus-Komplex.
Dieser Meilenstein spiegelt unser kontinuierliches Engagement für die Unterstützung von diagnostischen Laboren und dem verantwortungsvollen Umgang mit antimikrobiellen Wirkstoffen wider.
Die genannten Produkte sind in Kürze erhältlich und mit dem MAST® DISCMASTER® Dispenser kompatibel, der eine Gebrauchsstabilität der Produkte von bis zu 28 Tagen gewährleistet.